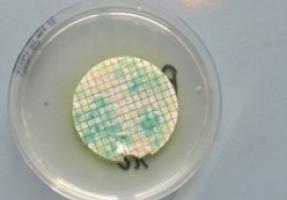
Foto

| 04.03.2026 |
 | Betriebsbesichtigung Kansai Helios |
| 16.05.2025 |
 | Chemie-Wettbewerb: Wir haben gewonnen! |
| 10.04.2025 |
 | Vitamin Cocktail Wahlpflichtfach Chemie 8BCD und 7BD |
| 05.05.2025 |
 | Chemie-Wettbewerb "Green Chemistry" |
| 24.04.2025 |
 | Vortrag Mag. Hozzank |
| 28.03.2025 |
 | Betriebsbesichtigung Donau Chemie |
| 28.02.2025 |
 | Mitmachlabor 4abd |
| 11.02.2025 |
 | 18. Projektwettbewerb "Green Chemistry" – Wir nehmen teil! |
| 02.12.2024 |
 | 4G besucht mit CH das Vienna Open Lab |
| 19.12.2024 |
 | Besuch bei Esarom: Eine Reise in die Welt der Aromen |
| 25.06.2024 |
 | DNA-Detektiv:innen unterwegs im Vienna Open Lab 3E |
| 25.04.2024 |
 | Immer was los im Wahlpflichtfach Chemie! |
| 18.04.2024 |
 | WPF BIUB × WPF CH - Treffen sich Biologie und Chemie… |
| 25.05.2022 |
 | (Fr)Eier Fall und weitere Eggsperimente im Naturwissenschaftlichen Labor |
| 11.05.2021 |
 | Projektwettbewerb des VCÖ - 4. Klassen |
| 31.01.2020 |
 | 8A experimentiert im VIENNA OPEN LAB |
| 23.05.2019 |
 | 4A - „Gummibärli selbstgemacht“ |
| 12.04.2019 |
 | 4B: „Gummibärli selbstgemacht“ |
| 26.03.2019 |
 | 5A besucht das VIENNA OPEN LAB |
| 02.09.2018 |
| VWA-Prämierung |
| 29.11.2017 |
 | Ausflug zu Esarom |
| 30.07.2017 |
 | Ehrenpreis für Florian Hahn |
| 22.06.2017 |
 | Exkursion der 7ABC nach Leoben |
| 14.06.2016 |
 | Chemieausflug 7. Klassen |
| 09.06.2016 |
 | Baustoffe 4D – „Dein eigenes Projekt!“ |
| 05.06.2016 |
 | Säuren und Basen im Haushalt |
| 21.06.2016 |
 | T-Shirts färben mit der 4A |
| 22.06.2016 |
 | Kosmetik selber machen 4B |
| 31.05.2016 |
 | „Gift- Projekt“ der 4A |
| 03.05.2016 |
 | Großer Erfolg für Schülerinnen und Schüler der 4. Klassen im Fach Chemie |
| 15.12.2015 |
 | Badesalze |
| 11.12.2015 |
 | Atommodelle von Schülerinnen und Schülern der 4. Klasse |